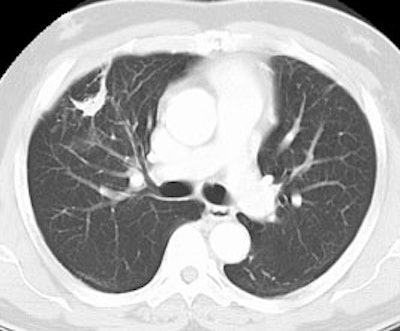
False Pos Neo Ct

Neotect (99mTc-Depreotide) (P-829)
Clinical problem:
Lung cancer is the primary cause for cancer mortality in the USA. It is the second most common cancer in men and the third most common cancer in women. It is the most common cause of cancer mortality among men and the second most common cause of mortality among women.
Early detection of lung carcinoma lowers morbidity and mortality. Significant improvement in quality of patient's life results for early detection of lung carcinoma. Current diagnostic tools available include sputum cytology, chest radiography, chest computed axial tomography, bronchoscopy and positron emitted tomography. More invasive procedures include computed axial tomography guided percutaneous biopsy, bronchoscopic biopsy, video assisted thoracoscopic biopsies and open lung surgery.
Currently, positron emitted tomography (PET) is approved by the FDA for the evaluation of lung carcinoma as well as mediastinal metastatic involvement, howeverthere is still limited availability of PET scanners nationwide. A new alternative diagnostic radiopharmaceuticalhas recently been approved for the detection of Non-Small Cell Lung Carcinoma (NSCLCA). This newradiopharmaceutical is depreotide. The following is a more detailed discussion of this new agent.
Chemistry and Pharmacology:
Depreotide is a synthetic somatostatin analog with high affinity for binding to somatostatin receptors subtypes 2,3, and 5 [2]. Somatostatin is primarily a down-regulatory peptide and somatostatin receptors are expressed in normal tissue [2]. Somatostatin receptors can be over-expressed in malignant tumors (including lung cancers) and some inflammatory processes (epithelioide cells in infectious and non-infectious granulomatous processes) [2]. Depreotide has the ability to form a stable ligand with Tc-99m which permits its use in gamma imaging [2]. The usual dose of 15-20 mCi of Tc99m-Depreotide is administered intravenously. It's structural formula is included below:

DEPREOTIDE (P829)
Patient Instructions
- Adequate patient hydration is encouraged to minimize the radiation absorbed dose to the kidneys and urinary bladder. Frequent voiding during the few hours after injection is encouraged. Ingestion of a minimum of 8 oz. of water is recommended prior to the examination.
- For up to 12 hours after admininstration, it is recommended to flush the toilet several times after use. If blood, urine or feces came in contact with clothing, it should be washed separately.
Imaging Protocol
The major goal is to further evaluate a parenchymal abnormality within the lung, for differentiation between a benign and malignant process. Our target is the evaluation of the lung parenchyma using planar as well as SPECT capabilities.
- Obtain a medical history to include previous allergic reactions or any history of anaphylactic reactions. History of previous neotect or other intravenous polypeptide injections is pertinent.
- Infuse Neotect through a peripheral vein as a single dose of 15 to 20 mCi containing approximately 50 µg of Tc99m radiolabeled Depreotide peptide. The current manufacturer recommendation suggest drawing one dose per vial. Although rare caution against hypersensitivity reaction should be taken and appropriate medications and equipment to treat these reactions should be available. There is an approximately <5% incidence of minor reactions.
- Tc99m Depreotide should not be injected into total parenteral nutrition admixtures or through total parenteral nutrition administration lines as it may form a complex glycosyldepreotide conjugate.
- Use a large field of view camera.
- Set photopeak at 140 KeV =/- 10%.
- SPECT acquired in a 128 x 128 matrix.
- Anterior/posterior planar images of the chest may be acquired 2-4 hrs after intravenous administration of Tc99m-Depreotide.
- Chest SPECT may be performed at 2-4 hrs after intravenous administration.
Interpretation
Good image interpretation requires anatomical knowledge, in this case evaluation of lung nodules requires knowledge of chest anatomy, expected sites of metastasis, and more experience in interpretation than is usually expected for simpler procedures. Excellent imaging technique and processing are prerequisites for adequate interpretation. Side by side interpretation of planar and cine images with comparison anatomical imaging in identical slice sequence is invaluable.
- Planar images of the chest or other anatomical areas in question are aqcquired between 2-4 hrs after Neotect administration. It is important to tailor the SPECT to areas of possible abnormality detected on the planar images. Additionally, the areas of noted parenchymal abnormalities on other imaging modalities such as computed tomography (CT) or magnetic resonance imaging (MRI) have to be included in the gamma camera field of view, this information has to be conveyed to the technologist performing the examination. Subtle abnormalities may not be detected on the planar images.
- Carefully evaluate the lung parenchyma. Asymmetric activity on delayed images is abnormal. Mild homogeneous, symmetric blood pool mediastinal activity on early and late images is normal, whereas even minor asymmetric, focal activity is not. Focal mediastinal asymmetry is suggestive of metastatic involvement, however we caution the use of this agent for detection of nodal metastatic involvement as this is a study in progress. Neotect has not yet been approved by the FDA for evaluation of metastatic lung carcinoma to the mediastinal lymph nodes.
- False positives:
- Active inflammatory processes like coccidiomycosis, histoplasmosis, tuberculosis, sarcoidiosis.
- Chronic inflammation
- Parenchymal hamartoma
- Parenchymal fibrosis
- Infectious processes such as abscess and pneumonia
- SPECT artifacts (flood inhomogeneities, noisy images)
- Normal biodistribution of Tc99m-Depreotide, like normal osseous structures such as rib ends (Attention to skeletal anatomy needed, other imaging modalities may be used).
Indications for the Neotect exam:
Preoperative evaluation in patients with a lung lesion identified on chest radiographs or computed tomography (CT) which has a intermediate or high malignant probability of malignancy:
Nodules as small as 8 mm have been detected and proven malignant [2]. For the evaluation of pulmonary nodules, Neotect has been shown to have a sensitivity between 93% to 96.6% and a specificity of 73% to 88% [1,2]. However, the incidence of malignancy in the patient population studied was high (77% [2]) and this may falsely enhance the exams sensitivity. Specificity suffers from false positive exams associated with active parenchymal inflammatory disease which on occasion can over-express somatostatin receptors [1,2]. A false positive exam has also been reported with a pulmonary hamartoma [2]. Positive predictive value is 87% and negative predictive value is 93% [1].
|
True positive Neotect exam: CT scan demonstrated an irregular nodule within the right upper lobe. Coronal Neotect image demonstrated abnormal tracer accumulation in the lesion. The lesion was surgically resected and found to be NSCLC. Case courtesy Dr. Jamie Montilla. |
|
|
|
False positive Neotect exam: CT scan demonstrated an irregular nodule within the right middle lobe. Transaxial Neotect image demonstrated abnormal tracer accumulation in the lesion. The lesion was surgically resected and found to be related to fibrosis and chronic inflammation. Although very sensitive, the Neotect exam does suffer from a lower specificity and the potential for false positive exams. Case courtesy Dr. Jamie Montilla. |
|
|
Dosimetry
The critical organ is the kidneys with an estimated absorbed radiation dose of 0.33 rad/mCi (0.090 mGy/MBq), assuming an average urinary bladder emptying time of 4.8 hrs after administration of 15-20 mCi of Tc99m-Depreotide. The effective dose equivalent is 0.023 mSv/MBq (0.084 rem/mCi).
Complications/Side Effects:
In clinical studies involving 647 patients who recieved 15-20 mCi of Tc99m-Depreotide 4.5% developed at least one adverse event. Headache and dizziness were experienced in 2% of the cases, nausea was experienced in 0.6% of the cases and flushing was seen in 0.5% of the cases. Overall, headache was the most common adverse event, recorded in 1.0% of cases.
HAMA Formation (Immunogenicity)
Administration of Neotect may induce hypersensitivity reactions or anaphylactic reactions, like other injected small peptides. However, in preliminary studies of 18 subjects no increased IgG or IgM were produced after 3 weeks following intravenous injection. Future studies will have to be performed.
REFERENCES:
(1) Seminars of Ultrasound, CT and MRI 2000. Goldsmith SJ. Role of nuclear medicine in the evaluation of the solitary pulmonary nodule. 21:129-138
(2) Chest 2000; Blum J, et al. A multicenter trial with a somatostatin analog 99mTc depreotide in the evaluation of solitary pulmonary nodules. 117: 1232-1238